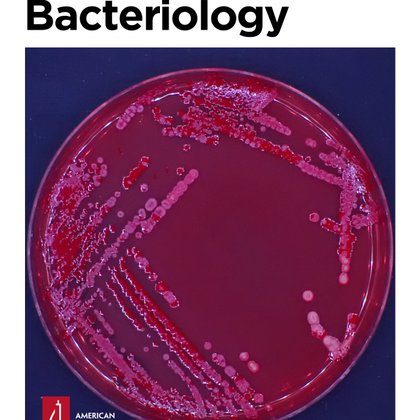
Tweet card summary image

Salim T. Islam Research Group
@IslaMyxoLab
Followers
309
Following
907
Media
103
Statuses
502
Extracellular Bacterial Interactions Lab at @inrsciences Our favourite bug? Myxococcus xanthus, "the E.coli of development" #myxo
Montreal (Laval), Canada
Joined February 2020
More "not science": THE TORONTO BLUE JAYS ARE HEADING TO THE WORLD SERIES!!!!!!!!!⚾️🧢💙😃
0
0
0
Even better than science!
0
0
1
Our group review on the history of #Myxococcus xanthus as a model organism ( https://t.co/GdNIKQHAbf) made the cover of the Journal of Bacteriology!!!
0
3
19
It's here! Celebrating 50 y of the MyxoMeeting, we myxologists teamed up & wrote a JBac group review on the history of #Myxococcus xanthus & how it became the coolest model bacterium ever 🦠🧫. Really proud of this 1, check it out for tons of useful info!
journals.asm.org
Myxobacteria are diverse, rod-shaped Gram-negative bacteria found in terrestrial and aquatic environments worldwide (1). A major claim to fame of these microorganisms is that the life cycle of...
1
3
13
It's here! Celebrating 50 y of the MyxoMeeting, we myxologists teamed up & wrote a JBac group review on the history of #Myxococcus xanthus & how it became the coolest model bacterium ever 🦠🧫. Really proud of this 1, check it out for tons of useful info!
journals.asm.org
Myxobacteria are diverse, rod-shaped Gram-negative bacteria found in terrestrial and aquatic environments worldwide (1). A major claim to fame of these microorganisms is that the life cycle of...
0
0
4
Sometimes I have too much fun working on review articles😁! Hmmm, how to end off a group review on the history of Myxococcus xanthus as a model 🦠? "The remarkable research journey of M. xanthus can thus be summed up as follows: from a pile of poop to getting shit done!"
1
0
1
Our Resource Allocation grant for computing 💻 allotment was approved, at double the amount from last year! 😃 Thnx @Alliance_Can! Time for some even cooler #moleculardynamics simulations!!! Stay tuned... 😉
2
0
8
Please repost: Postdoc position in antibiotic discovery in a multidisciplinary project w. high-throughput approaches, microscopy, AI, and hit-to-lead optimization @UMontreal @med_umontreal @Mila_Quebec @IRIC_umontreal. Apply @ ML.Antibiotics@gmail.com. See https://t.co/2DjrErxpqw
4
44
83
Our recently work shedding light on the reason why most OAg in E. coli favoured the initial sugar with GlcNAc same to ECA structure is out! It is like a plumbing solution to ensure efficient recycling of the essential cell envelope building block, UndP https://t.co/z3mmpS5kj0
journals.plos.org
Author summary Enzymes involved in bacterial polysaccharide biosynthesis have substrate specificity to ensure the correct polysaccharide is produced at the appropriate place and time. However, this...
2
7
16
We shown the very first quantitative evidence to localise the sequestration of C55 oligosaccharide intermediates to the cytosolic face of the cytoplasmic membrane. Thanks @MicrobioSoc for giving the concise story a good home. https://t.co/XnQYOSnaiu
microbiologyresearch.org
1
2
7
Delighted to share our bTB in bison story. Great partnership between Parks Canada and @VIDOInterVac with exceptional assistance from VIDO veterinary services team. https://t.co/iUvSsVuv5k
nature.com
Scientific Reports - Orally administered live BCG and heat-inactivated Mycobacterium bovis protect bison against experimental bovine tuberculosis
4
2
12
Excited to announce: I'll be joining the Editorial Board of the Journal of Bacteriology! 🦠🧫🔬 @JBacteriology, published by @ASMicrobiology since 1916, has long been a home for solid bacteriology research. It has been a pleasure to review for them over the years!
4
1
42
Shhhhhhh.... 🤫 *whispers* Nobody tell @InnovationCA or @NSERC_CRSNG RTI, ok?...🙊 https://t.co/3NUNRKu83W
yankodesign.com
If there's one corner of the internet I find myself constantly visiting, it's the LEGO Ideas website just to see what unique stuff people are building. You usually see a healthy mix of submissions -...
0
0
2
So true & prescient! For shits & giggles, I've long planned to write up 1 of our stories currently in the pipeline using the leftside format (at least for the preprint), detailing the actual sequence of events that led to the final conclusion. Brace yourselves for an epic Fig.1🤓
0
0
2
Not science-related, but this is just too perfect not to re-post. If you know, you know... #Shatkins
1
0
0
It has arrived!😃🤓 Even our librarian couldn't track down an e-copy, so I ordered one from the UK. Has an excellent summary of early myxobacterial research, especially re: #motility🦠🔬 Discovered new (old!) references that show how ideas from 1951 turn out to be true after all!
4
1
13
Sharing a very short paper that I wanted to write up for many years which showed biochemical evidence that UndP sequestered with altered sugar structures are trapped at the cystosolic face of the membrane due to ineffective Wzx activity.
biorxiv.org
In the predominant Wzx/Wzy-dependent bacterial surface polysaccharide biosynthetic pathway, synthesis is divided between the cytoplasmic and periplasmic faces of the membrane. Initially, an oligosa...
1
6
10
The cobra chicken is not to be trifled with! You don't know fear until you turn around on the 4th fairway to see one gliding at you from 10ft away, 5ft off the ground, making a beeline for your head, and all you have to defend yourself with is the 7-iron you have in your hand...
0
0
3
🇨🇦 Happy Canada Day 🇨🇦 to all of my fellow hosers out there! Just hangin' out and takin' it easy this long weekend... #OhCanada #hammocklife #LandShark
0
0
7